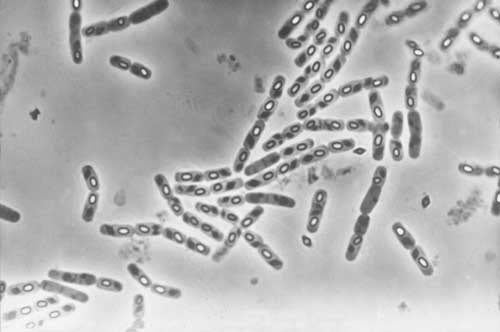

Hama muncul hampir di setiap lingkungan, mulai dari pertanian, perkotaan, hingga rumah tangga. Serangga perusak tanaman, nyamuk penyebar penyakit, dan kecoa yang merusak sanitasi secara langsung menurunkan kualitas hidup manusia.
Selama bertahun-tahun, penggunaan pestisida kimia menjadi cara utama untuk menekan populasi hama. Namun, dampak negatifnya terhadap lingkungan, kesehatan manusia, dan resistensi hama mendorong perlunya alternatif yang lebih ramah lingkungan. Salah satu solusi yang berkembang pesat adalah pengendalian hama menggunakan mikroba.
Pengendalian hama dengan mikroba berarti memanfaatkan mikroorganisme yang secara alami menyerang serangga atau organisme pengganggu. Praktisi biasanya menggunakan bakteri, jamur, dan virus. Mikroba ini menginfeksi tubuh hama, melemahkan sistem pertahanan, lalu menyebabkan kematian.
Mekanisme Kerja Mikroba
Setiap kelompok mikroba memiliki mekanisme kerja berbeda. Bakteri seperti Bt biasanya menghasilkan racun yang menyerang saluran pencernaan hama. Jamur entomopatogen, seperti Beauveria bassiana dan Metarhizium anisopliae, menempel pada kutikula serangga, lalu menembus tubuhnya hingga menyebabkan infeksi. Virus, misalnya nukleopolyhedrovirus (NPV), menyerang jaringan dalam tubuh larva serangga dan menyebar cepat dalam populasi.
Mekanisme ini memungkinkan pengendalian hama yang lebih spesifik, sehingga risiko terhadap organisme non-target, termasuk manusia, relatif rendah.
Kelebihan Pengendalian Mikroba
Bakteri Bacillus thuringiensis israelensis (Bti). Sumber: Alchetron
Salah satu keunggulan utama pengendalian hama dengan mikroba adalah sifatnya yang ramah lingkungan. Mikroba tidak meninggalkan residu berbahaya, berbeda dengan pestisida kimia yang dapat mencemari tanah dan air.
Selain itu, mikroba cenderung menargetkan hama spesifik sehingga tidak berbahaya terhadap serangga bermanfaat seperti lebah atau musuh alami hama lainnya. Dari sisi resistensi, penggunaan mikroba dapat mengurangi risiko terjadinya ketahanan hama karena mekanisme infeksi mikroba lebih kompleks dibanding zat kimia tunggal.
Pada banyak kasus, praktisi mengombinasikan pengendalian mikroba dengan metode lain dalam program Pengendalian Hama Terpadu (PHT). Misalnya, mereka menggunakan jamur entomopatogen bersama pelepasan predator alami untuk menekan populasi serangga secara lebih efektif.
Pengendalian hama berbasis mikroba relevan di berbagai bidang, bukan hanya pertanian. Dalam pengendalian nyamuk di perkotaan, misalnya, praktisi memakai bakteri Bacillus thuringiensis israelensis (Bti) untuk membunuh larva nyamuk di sumber air. Di sektor hortikultura, jamur seperti Beauveria bassiana mampu menekan populasi kutu daun. Bahkan di lingkungan domestik, peneliti mengembangkan jamur entomopatogen untuk mengendalikan kecoa dan rayap. Fleksibilitas ini menjadikan teknologi tersebut cocok diterapkan di berbagai lokasi, tidak terbatas pada lahan pertanian.
Tantangan Implementasi
Meskipun menjanjikan, penggunaan mikroba sebagai pengendali hama memiliki tantangan. Faktor lingkungan seperti suhu, kelembaban, dan paparan sinar UV dapat memengaruhi efektivitas mikroba. Sebagai contoh, jamur entomopatogen membutuhkan kelembaban tinggi untuk berkembang optimal, sementara bakteri Bt lebih efektif pada larva tahap awal dibandingkan larva tahap akhir.
Selain itu, penerapan mikroba sering kali memerlukan teknik aplikasi khusus agar dapat bekerja maksimal. Misalnya, penyemprotan jamur entomophatogen perlu diarahkan ke bagian tanaman tempat hama banyak beraktivitas.
Tantangan lain adalah adopsi oleh pengguna. Petani, pengelola bisnis, atau masyarakat umum mungkin lebih terbiasa dengan pestisida kimia yang bekerja cepat. Oleh karena itu, diperlukan edukasi agar penggunaan mikroba dapat diaplikasikan lebih luas.
Dengan pendekatan yang tepat, integrasi mikroba dalam program PHT dapat memberikan hasil yang berkelanjutan, menekan populasi hama tanpa mengganggu keseimbangan ekosistem.
Nah, demikian ulasan terkait pengendalian hama menggunakan mikroba. Semoga bermanfaat ya!
Author: Ainur Subhan
Editor: Sinta
Referensi:
Ravensberg, W. J. (2011). Implementation of a microbial pest control product in an integrated pest management programme. In W. J. Ravensberg, A roadmap to the successful development and commercialization of microbial pest control products for control of arthropods (pp. 235–254). Springer. https://doi.org/10.1007/978-94-007-0437-4_6

